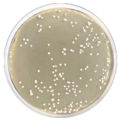

Kultivační půda používaná pro pěstování náročných patogenů a jiných mikroorganismů. Tento produkt je dodáván v dehydratované formě a je určen pro přípravu hotových kultivačních médií.

Želírující prostředek pro přípravu kultivačních médií. Tento produkt je dodáván v dehydratované formě a je určen pro přípravu hotových kultivačních médií.

Kultivační půda používaná pro test citlivosti na antibiotika a sulfamidy (disková, difúzní Kirby-Bauer metoda) a pro primární izolaci neisserií a dalších patogenů z klinických vzorků. Tento produkt je dodáván v dehydratované formě a je určen pro přípravu hotových kultivačních médií.

Kultivační půda s přesně definovaným chemickým složením určená pro kultivaci hub a bakterií, nabízející dusičnan sodný jako jediný zdroj dusíku.
Produkt je dodáván v dehydratované formě a je určen pro přípravu hotových kultivačních médií.
Selektivní médium používané pro izolaci a kultivaci patogenních kvasinek a plísní, zejména pak dermatofytů a kyselinotvorných miktoorganismů. Tento produkt je dodáván v dehydratované formě a je určen pro přípravu hotových kultivačních médií.

Médium používané pro identifikaci a diferenciaci enterobakterií na základě jejich schopnosti fermentovat sacharidy a tvořit H2S.
Produkt je dodáván v dehydratované formě a je určen pro přípravu hotových kultivačních médií.

Selektivní médium pro izolaci a kvantifikaci koliformních bakterií v mléčných produktech, vodě a potravinách. Tento produkt je dodáván v dehydratované formě a je určen pro přípravu hotových kultivačních médií.

Kultivační půda používaná pro izolaci a identifikaci enterobakterií ze stolice, moči, odpadních vod a potravin. Tento produkt je dodáván v dehydratované formě a je určen pro přípravu hotových kultivačních médií.

Kultivační půda pro stanovení celkového počtu aerobních mikroorganismů v mléce a dalších látkách hygienického významu metodou vylévání ploten dle ISO 4833:2003. Tento produkt je dodáván v dehydratované formě a je určen pro přípravu hotových kultivačních médií.

Pro kultivaci rekombinantních kmenů E. coli a pro růst vláknitých bakteriofágů. Tento produkt je dodáván v dehydratované formě a je určen pro přípravu hotových kultivačních médií.

Mikobiologická půda určená pro kultivaci a kvantifikaci gramnegativních bakterií z čeledi Enterobacteriaceae zejména ze vzorků vody a potravin. Tento produkt je dodáván v dehydratované formě a je určen pro přípravu hotových kultivačních médií.

Médium pro kultivaci plísní a kvasinek z různých materiálů, zejména pak mléka a mléčných produktů. Tento produkt je dodáván v dehydratované formě a je určen pro přípravu hotových kultivačních médií.

Kultivační půda určená pro detekci a kvantifikaci Clostridium perfringens ve vzorcích.
Produkt je dodáván v dehydratované formě a je určen pro přípravu hotových kultivačních médií.

Tekuté médium využívané po přidání glycerolu pro kultivaci rekombinantních kmenů E. coli. Tento produkt je dodáván v dehydratované formě a je určen pro přípravu hotových kultivačních médií.

Brain Heart Infusion Broth je určen pro růst patogenních koků a dalších mikroorganismů. Tento produkt je dodáván v dehydratované formě a je určen pro přípravu hotových kultivačních médií.

Tekuté kultivační médium používané pro stanovení schopnosti mikroorganismů fermentovat vybrané sacharidy. Tento produkt je dodáván v dehydratované formě a je určen pro přípravu hotových kultivačních médií.

Suplement pro přípravu selektivního agaru pro Bacillus cereus (LC1124) dle normy ISO 7932:2004.

Obohacující látka pro přípravu Baird-Parkerova média podle normy ISO 6888-1.